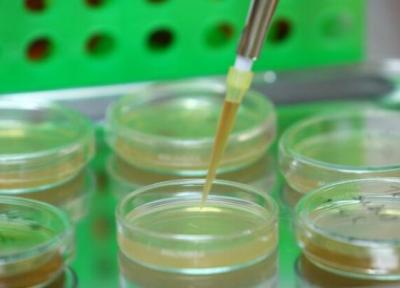

آخرین ارسال ها در وبلاگ های یومی بلاگ | صفحه 122

چرا داشتن زمان تنهایی برای سلامت روان لازم است؟
بسیاری از افراد تمایل دارند زندگی اجتماعی داشته باشند و تحقیقات نشان داده است که ارتباطات اجتماعی برای رفاه عاطفی و جسمی حیاتی است. با این حال، داشتن زمان تنهایی هم نقشی اساسی در سلامت روان دارد. بودن در کنار دیگران مزایای مختلفی دارد اما استرس هم ایجاد...

داستان سلیمه را در لیان دخت بخوانید
انتشارات صاد کتاب لیان دخت اثر ثریا شیری را منتشر نموده است.

برترین رستوران ها و کافه های فست فود مسکو
رستوران های فست فود متعددی نظیر رستوران مردم و پاستا، لافا لافا، شوک مارکت و... در مسکو وجود دارد که در زمان های عجله ای می تواند گزینه مناسبی برای رفع کردن گرسنگی باشد.

گنبد قابوس در جدال با علف های هرز
رشد علف های هرز روی سقف میراث جهانی هزار ساله گنبد قابوس، نیازمند موارد نیازمند رعایت اصول مرمتی است.
استخراج ماده وراثتی با کیت های ایرانی ممکن شد
به گزارش خبرنگاران به نقل از معاونت علمی و فناوری ریاست جمهوری، پرویز شایان مدیرعامل این شرکت دانش بنیان با بیان اینکه یکی از محصولات این واحد فناور، فراوری مجموعه کیت های استخراج ماده وراثتی از انواع نمونه های زیستی است، گفت: سلول و بافته های انسانی،...

چگونه بدون داشتن دوچرخه به یک تور دوچرخه سواری برویم؟
گردشگری به عنوان یک صنعت خیلی بزرگ شناخته می شود و برای اینکه یه تور گردشگری برگزار شود، چیزهای مختلفی کنار هم قرار می گیرند تا به شما حس سفر را منتقل نمایند.

10 قانون نانوشته آداب معاشرت، در فرهنگ های گوناگون
تفاوت فرهنگ ها در جهان باعث شده تا هر جامعه ای، آداب معاشرت خاص خود را داشته باشد؛ اما 10 مورد از آداب معاشرت در فرهنگ های جوامع گوناگون وجود دارند که نانوشته هستند و به طور یکسان اجرا می شود.

مسیرهای خطوط اتوبوسرانی منتهی به محل حادثه پلاسکو تغییر کردند
بعضی خطوط اتوبوسرانی و تاکسیرانی با تغییر جهت روبرو شده که این امر ممکن است تا اواسط هفته آینده تداوم داشته باشد.

چند شب اقامت در کنار زرافه ها
عمارت زرافه یکی از هتل های دنیا در حومه نایروبی، مرکز کنیا که به مهمانان خود فرصت معاشرت با زرافه ها را می دهد.

ابرسیج، روستای جهانی نمدمالی
روستای ابرسج، قطب تولید نمد در استان سمنان به عنوان روستای جهانی نمدمالی معرفی می شود.

جهش تازه و بسیار خطرناکم ویروس اچ آی وی کشف شد
پژوهشگران دانشگاه آکسفورد اعلام کردند، سویه نو ویروس اچ آی وی را در هلند کشف کردند که بسیار خطرناک تر از سویه های قبلی ویروس است.

تصاویری از پل عجیب و گیج کننده در چین
یک پل در چین که در سال 2017 معرفی و سال 2020 افتتاح شد و طراحی خاص و گیج کننده ای دارد.

دریاچه لوسرن، لذت قایق سواری در سوئیس
دریاچه لوسرن در کجا قرار گرفته است؟دریاچه لوسرن حدوداً در مرکزی ترین نقطه کشور سوئیس است. نام این دریاچه برگرفته از شهریست که در آن واقع شده یعنی شهر لوسرن، که در 40 کیلومتری آن قرار گرفته است. اگر به تماشا این کشور زیبا علاقمند هستید از تور اروپا نوروز...

برای رسیدن به موفقیت فقط این 4 کار را انجام دهید!
راه هایی رسیدن به پیروزیتچقدر خوب هست در جهت زندگی مان به راهی که آدم های پیروز رفتند نگاه کنیم و تجربه های آنها را مرور کنیم. تجربه های که گاه به نظر می رسید برای خیلی از ما دور و دست نیافتنی است. خیلی از این آدم های پیروز هیچ گاه فکر نمی کردند روزی در این...

طرز تهیه چیپس و پنیر در خانه؛ پرانرژی گاهی هم مضر
گاهی وقت ها دیگر نمی دانیم باید چه غذایی باید درست کنیم و از همه غذا های تکراری کلافه می شویم؛ این وقت ها می توانیم سراغ غذا هایی برویم که هرچند می توانند مضر باشند، اما برای لحظاتی حالمان را خوب می نمایند و در کنارش می توانند مفید هم باشند. یکی از این غذا...

شروع پروازهای نوروزی از 25 اسفند
پروازهای نوروزیبا فرا رسیدن سال نو و شروع تعطیلات نوروزی شمار مسافران افزایش چشمگیری پیدا می نماید. بسیاری از خانواده ها از ماه ها قبل برنامه ریزی می نمایند تا این چند روز تعطیل را همراه با خانواده به سفرهای نوروزی بفرایند. پرواز و سفر با هواپیما بخشی...

قم موقعیت مکانی ممتازی برای فعالیت های تجاری دارد
دریکوندی گفت:استان قم به دلیل نزدیک بودن به عمده بازار های مصرف و همچنین مهمترین راه های مواصلاتی کشور، موقعیت مکانی ممتازی برای توسعه فعالیت های تجاری دارد.

معرفی هتل آکوا فانتزی کوش آداسی ، 5 ستاره
یکی از هتل های مجذوب کننده 5 ستاره در کوش آداسی، آکوا فانتزی است که در فاصله 3 دقیقه ای از دریا قرار گرفته و اطراف آن را جنگل احاطه کرده است. هتل آکوا فانتزی کوش آداسی یک پارک آبی فوق العاده دارد که شاید مهمترین ویژگی آن است. اتاق های هتل همگی روشن و مدرن...

سولدو: فوتبال را با گل زدن دنبال می کنیم نه مالکیت توپ
سرمربی تراکتور تبریز با بیان اینکه فوتبال را با گل زدن دنبال می کنیم نه مالکیت توپ، گفت: در بازی با نفت مسجدسلیمان می توانستیم به گل های زیادی برسیم.

فروش خودرو قسطی نداریم
به گزارش خبرنگاران، درپی طرح موضوع فروش محصولات ایران خودرو به صورت اقساطی، این گروه صنعتی در اطلاعیه ای موضوع را تکذیب و اعلام کرده است که در حال حاضر طرح فروش خودرو به صورت قسطی ندارد.